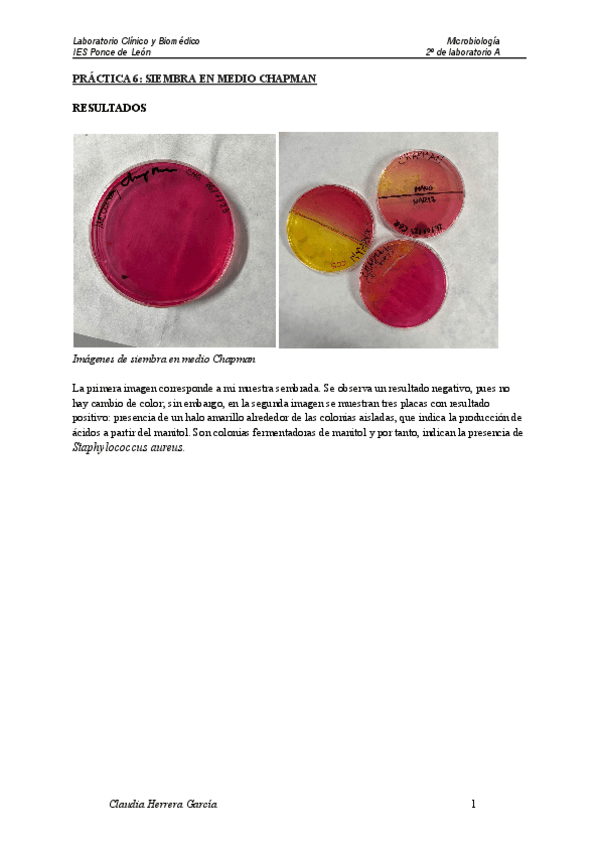
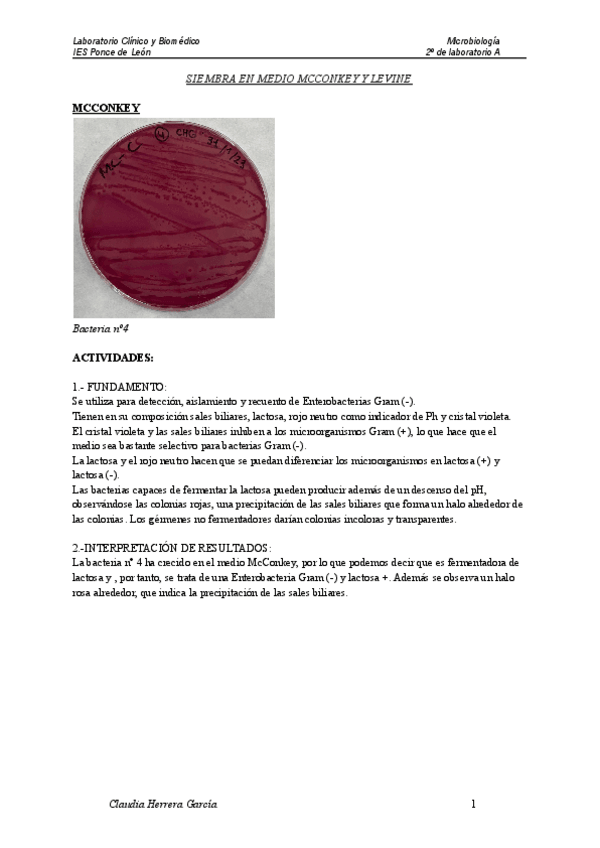
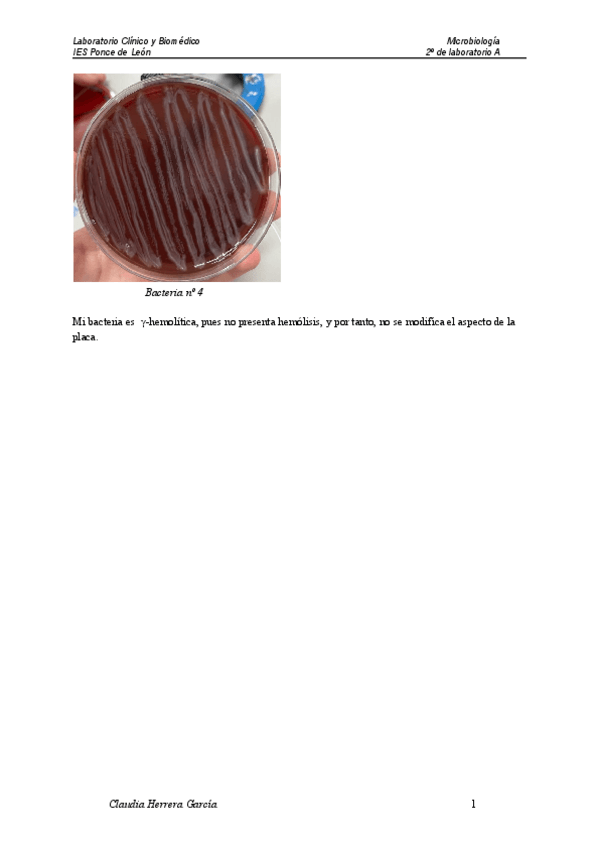
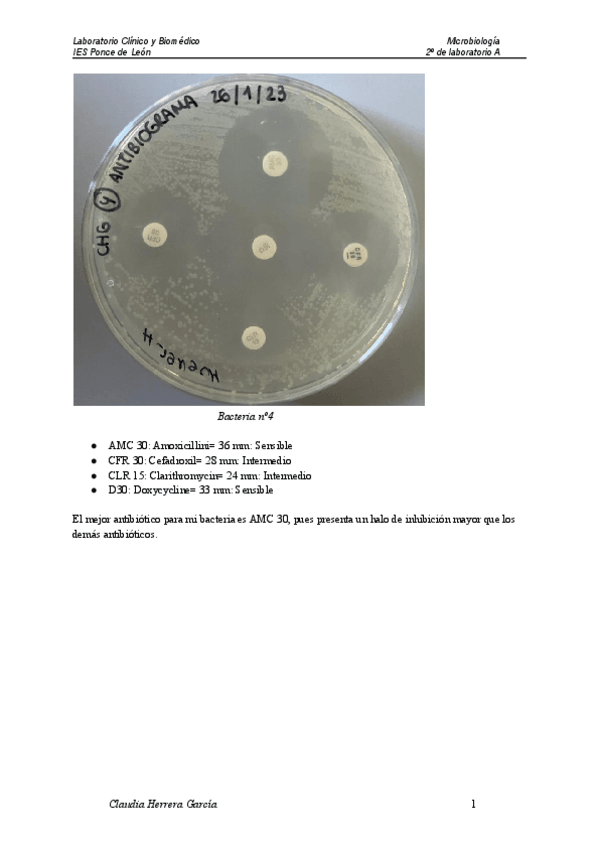

Microbiología clínica
practicas
-
Técnicas de siembra
He publicado nuevos practicas de Microbiología clínica: Técnicas de siembra
He publicado nuevos practicas de Microbiología clínica: Elaboracion-De-Medios-De-Cultivo.pdf
He publicado nuevos practicas de Microbiología clínica: Practica-Esterilizacion.pdf
He publicado nuevos practicas de Microbiología clínica: Preparacion-De-Colorantes.pdf
He publicado nuevos practicas de Microbiología clínica: Practica-Reconocimiento-De-Material.pdf
He publicado nuevos apuntes de Microbiología clínica: PRACTICA-9-PRUEBA-DE-LA-OXIDASA.pdf
He publicado nuevos apuntes de Microbiología clínica: P2-PRUEBA-DE-OXIDACION-FERMENTACION-HUGH-Y-LEIFFSON.pdf
He publicado nuevos apuntes de Microbiología clínica: PRACTICA-8-PRUEBA-DE-AGAR-HIERRO-KLIGLER-1.pdf
He publicado nuevos apuntes de Microbiología clínica: P1-PRUEBA-DE-SCREENING-DE-PRODUCCION-DE-ACIDO-Y-GAS-1.pdf
He publicado nuevos apuntes de Microbiología clínica: PRACTICA-6-SIEMBRA-EN-MEDIO-CHAPMAN.pdf
He publicado nuevos apuntes de Microbiología clínica: PRACTICA-12-UREASA.pdf
He publicado nuevos apuntes de Microbiología clínica: PRACTICA-5-PRUEBA-DE-LAS-DESCARBOXILASAS.pdf
He publicado nuevos apuntes de Microbiología clínica: SIEMBRA-EN-MEDIO-MCCONKEY-Y-LEVINE.pdf
He publicado nuevos apuntes de Microbiología clínica: ROJO-DE-METILOVOGES-PROSKAUER.pdf
He publicado nuevos apuntes de Microbiología clínica: SIEMBRA-EN-AGAR-CLED.pdf
He publicado nuevos apuntes de Microbiología clínica: antifungigrama-1.pdf
He publicado nuevos apuntes de Microbiología clínica: CE-e-RESULTADOS-DEL-ENTEROPLURI-TEST.pdf
apuntes
-
Prácticas Microbiología
He publicado nuevos apuntes de Microbiología clínica: Prácticas Microbiología
apuntes
-
Resumenes Microbiología
He publicado nuevos apuntes de Microbiología clínica: Resumenes Microbiología
apuntes
-
MICROBIOLOGÍA CLÍNICA
He publicado nuevos apuntes de Microbiología clínica: MICROBIOLOGÍA CLÍNICA
He publicado nuevos apuntes de Microbiología clínica: Pruebas-de-identificacion.pdf
apuntes
-
Microbiología clínica
He publicado nuevos apuntes de Microbiología clínica: Microbiología clínica
He publicado nuevos apuntes de Microbiología clínica: T4-tecnicas-de-siembra-MICRO.pdf
He publicado nuevos apuntes de Microbiología clínica: T3Medios-de-cultivo-Micro-1.pdf
apuntes
-
MICRO
He publicado nuevos apuntes de Microbiología clínica: MICRO
apuntes
-
MICRO
He publicado nuevos apuntes de Microbiología clínica: MICRO
He publicado nuevos apuntes de Microbiología clínica: EL-LABORATORIO-DE-MICROBIOLOGIA.pdf

¡Estás al día!
Has visto todos los archivos